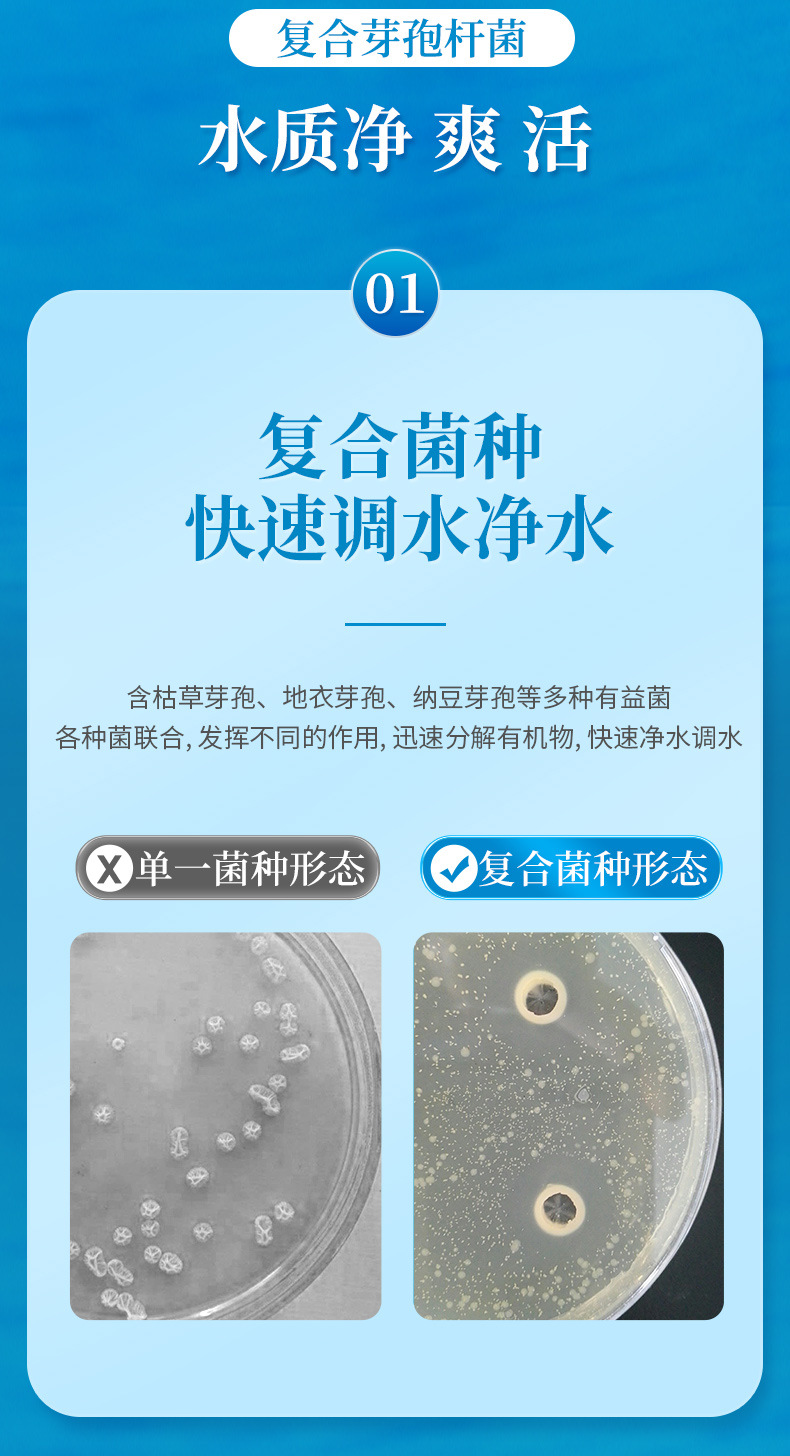

Комплекс Huaxu Bacillus subtilis для аквакультуры, специальные эм бактерии для рыбных и креветочных прудов, живые бактерии, пробиотические штаммы
Продано за 30 дней:
0 шт.
Всего продаж:
9985 шт.
Минимальное количество для заказа:
1 шт.
Комплекс Huaxu Bacillus subtilis для аквакультуры, специальные эм бактерии для рыбных и креветочных прудов, живые бактерии, пробиотические штаммы
от 187.25 ₽ за 1 шт.
-21%
187.25 ₽
Доставка по Китаю включена в цену
Оптом
от 1 шт.
187.25 ₽
от 5 шт.
137.25 ₽
от 10 шт.
124.75 ₽
Описание

Характеристики
Импортировать ли:
нет
Категория продукта:
Другие аквариумные принадлежности
номер товара:
Х2110009
Является ли это запатентованным источником товаров?:
нет
Заниматься ли исключительно поставками товаров для трансграничного экспорта:
нет
категория:
Аквариумное оборудование
О продавце
Имя:
Оценка сервиса:
4.0
Оценка логистики:
4.1
Оценка споров и жалоб:
5.0
Оценка предложения:
5.0
Оценка консультации:
0.0
repeatPurchasePercent:
0.4084862772151149
afterSalesExperienceScore:
5.0
qualityRefundWithin30Day:
0.0

Комплекс Huaxu Bacillus subtilis для аквакультуры, специальные эм бактерии для рыбных и креветочных прудов, живые бактерии, пробиотические штаммы
187.25 ₽
187.25 ₽




 Курс юаня: 12.5
Курс юаня: 12.5



